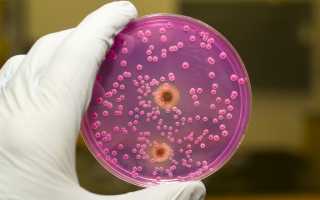
Пимафуцин при беременности. Свечи и таблетки. Инструкция по применению.

Такой препарат, как свечи Пимафуцин при беременности или таблетки Пимафуцин нередко назначают будущим мамам для лечения молочницы (а она, отметим, бывает у каждой третьей беременной хотя бы раз за 40 недель).
Разрешено ли применение данного препарата у будущих мам? Насколько оно эффективно справляется с поставленной задачей – вылечить молочницу?
Сначала о молочнице
Кандидоз, или как его еще называют «молочница» – едва ли не самое распространенное заболевание среди всех женщин, не исключение и беременные женщины. Возбудителем заболевания являются грибки – Кандида, увеличение числа которых и вызывает различные неприятные симптомы и воспаления. Возникает кандидоз обычно на фоне сниженного иммунитета, например, из-за простудных заболеваний или частого употребления антибиотиков.

Грибы Кандида
Если говорить о причинах, вызывающих молочницу, кроме вышеперечисленных, могут быть и следующие:
- заражение от полового партнера;
- наличие и размножение патогенных грибков в кишечнике;
- плохое питание;
- регулярное ношение синтетического нижнего белья.
Как же понять, что у вас молочница? Обратите внимание на основные симптомы:
- творожистые выделения из влагалища;
- светло-белые выделения с кисловатым запахом;
- раздражение наружных половых органов;
- зуд и жжение наружных половых органов и влагалища;
- дискомфорт во время мочеиспускания или полового акта.
Грибы семейства Кандида есть у всех женщин, только в норме они содержатся в минимальных количествах и неспособны принести вред. При снижении иммунитета их число увеличивается, и тогда возникают проблемы.
Если вы наблюдаете у себя один или несколько симптомов молочницы – стоит обратиться к врачу.
Мнение врача:
Пимафуцин является одним из безопасных препаратов для лечения вагинальных инфекций у беременных женщин. Свечи и таблетки этого препарата содержат активное вещество натамицин, которое обладает противогрибковым действием. Инструкция по применению подробно описывает способ введения свечей и дозировку таблеток, что делает использование препарата удобным и эффективным. Врачи рекомендуют соблюдать рекомендации инструкции и проконсультироваться с специалистом перед началом лечения, особенно в период беременности, чтобы избежать нежелательных последствий и обеспечить безопасность как для матери, так и для ребенка.
https://youtube.com/watch?v=nbIb6cYz9V8
Молочница при беременности
Молочница – неприятное заболевание в любой период, но оно может быть не просто неприятно, но опасно в период беременности. Почему? Кандидоз может оказаться губительным для нормального течения беременности. В некоторых случая он вызывает утончение оболочки плода (амниона) и провоцирует ее разрыв. И далеко не всегда это случается вовремя. Кроме того, при активном воспалении младенец, проходя по родовым путям, может заразиться молочницей.

Чаще всего молочница при беременности проявляется творожистыми выделениями из влагалища
По этим причинам лечение молочницы у будущих мам требует контроля врача и назначения исключительно безвредных препаратов, не влияющих на развитие плода и состояние здоровья самой женщины.
Если не обращаться за назначениями и контролем состояния заболевания к доктору, болезнь может перейти в хроническую стадию и вызвать необратимые изменения в организме, и даже привести к бесплодию.
Почему Пимафуцин?
Пимафуцин – современный медицинский препарат, который является противогрибковым антибиотиком широкого действия, грибы семейства Кандида к нему наиболее чувствительны. В состав Пимафуцина входит натамицин, который разрушает клетки грибов, тем самым убивая их. Препарат не проникает в кровь, а значит не пересекает маточно-плацентарный барьер, а значит никак не повлияет на развитие будущего малыша. Кроме того, лекарство используется дерматологами при грибковых инфекциях кожных покровов, может применяться у кормящих мам и даже младенцев.

Форма выпуска Пимафуцина
Выпускается Пимафуцин в удобных формах:
- вагинальные суппозитории или свечи Пимафуцин – действуют непосредственно на слизистую и имеют особую популярность именно у беременных женщин;
- таблетки Пимафуцин применяются обычно при хроническом Кандидозе или в тяжелых случаях, когда заболевание распространилось на брюшную полость. Таблетки покрыты оболочкой, которая растворяется не в желудке, а в кишечнике, что снижает риски побочных действий на желудок;
- крем Пимафуцин используется для местного наружного действия, действует на поврежденные участки кожи или слизистой; может использоваться партнером для предупреждения повтора заболевания.
Пимафуцин назначают не только при молочнице, но и при ряде других, не менее серьезных заболеваний. Это могут быть, как мы уже говорили, грибковые заболевания кишечника, кольпит, вульвит, вульвовагинит, дерматомикоз, микоз уха, грибковые заболевания ногтей и кожи.
Прием данного препарата осуществляется по назначению лечащего врача после сдачи анализов и подтверждения наличия патогенной микрофлоры в организме.

Опыт других людей
Пимафуцин – препарат, который часто применяется женщинами в период беременности для лечения грибковых инфекций. Многие будущие мамы отмечают его эффективность и безопасность при использовании. Свечи и таблетки Пимафуцин помогают быстро справиться с дискомфортом и восстановить здоровье в интимной зоне. Однако перед применением необходимо ознакомиться с инструкцией, чтобы избежать возможных побочных эффектов. Рекомендуется строго соблюдать дозировку и курс лечения, указанные в инструкции. При возникновении сомнений или неприятных ощущений следует проконсультироваться с врачом. В целом, Пимафуцин при беременности считается безопасным и эффективным средством для борьбы с грибковыми инфекциями.
Сроки применения Пимафуцина
Назначение, как и расчет дозировки препарата Пимафуцин производит лечащий врач исходя из того, насколько тяжело протекает заболевание.
Лечение таблетками Пимафуцин длится в среднем от семи до десяти дней, свечами – три – девять дней.
Лекарство употребляют курсом до исчезновения симптомов (и, возможно, пару дней после).
На время лечения женщины врачи обычно рекомендуют провести профилактику полового партнера с помощью крема Пимафуцин и отказаться от близости на весь период применения лекарства.
Пимафуцин при беременности
Пимафуцин разрешен к приему на протяжении всей беременности, начиная с первого триместра и заканчивая этапом подготовки к родам.
Обычно в I триместре врачи стараются максимально ограничить прием лекарств беременной женщиной, поскольку плацента еще не сформирована, и все компоненты в крои матери попадают к ребенку. Но даже в этом триместре разрешено использование Пимафуцина, так как он не всасывается в кровь и имеет местное действие. Обычно на этом сроке используют Пимафуцин в форме вагинальных суппозиториев.
Во II триместре, как в самом «безопасном» и благополучном, разрешается прием многих препаратов, запрещенных на ранних и поздних сроках беременности. Плод защищен, будущая мама спокойна. В этот период можно использовать «тяжелую артиллерию» и принимать таблетки от молочницы, если свечи не справляются.

Применение Пимафуцина безопасно во время беременности
В последний триместр врач может рекомендовать Пимафуцин в качестве профилактики заражения плода при родах, особенно если кандидоз проявлялся в ранние сроки.
Помните! Даже не смотря на безопасность препарата, Пимафуцин следует принимать строго по назначению врача и после обследования.
Лечащий врач определит степень тяжести заболевания и необходимую дозировку препарата. Не занимайтесь самолечением, ведь кажущиеся на первый взгляд признаки молочницы могут оказаться симптомами более серьезного заболевания, которое можно определить только после сдачи необходимых анализов.
Побочные действия и противопоказания приема Пимафуцина у беременных
Обычно данный препарат переносится женщинами легко и без последствий. В некоторых случаях возникают следующие побочные эффекты:
- зуд и жжение от приема Пимафуцина в форме вагинальных суппозиториев;
- раздражение, покраснение в местах соприкосновения препарата со слизистой;
- расстройство желудка и тошноту от употребления таблетированной формы;
- усиление признаков токсикоза и общее ухудшение самочувствия у беременных женщин.
Перечисленные побочные эффекты – редкость, и возникают они преимущественно по причине индивидуальной непереносимости компонентов препарата.
Если вы заметили у себя симптомы побочных действий Пимафуцина– прекратите прием лекарства и обратитесь к врачу.
Противопоказаний, кроме индивидуальной непереносимости препарата или его компонентов нет, т.к. действующее вещество натамицин, в кровь не проникает, а значит, и навредить будущей маме и плоду не может.
Частые вопросы
Можно ли пить таблетки Пимафуцин при беременности?
Возможно применение Пимафуцина® при беременности и в период грудного вскармливания. Нет данных о неблагоприятном влиянии препарата на плод.
Как правильно принимать Пимафуцин таблетки?
Внутрь. Прием пищи не оказывает влияния на эффективность препарата. При кандидозе кишечника взрослым рекомендуется принимать 1 таблетку 4 раза в сутки, детям – 1 таблетку 2 раза в сутки. Средняя продолжительность курса лечения – 1 неделя.
Сколько дней лечить молочницу Пимафуцином?
Как принимать, курс приема и дозировка Назначают по 1 вагинальному суппозиторию в течение 3-6 дней.
Как правильно вводить свечи Пимафуцин?
Назначают по 1 вагинальному суппозиторию в течение 3-6 дней. Суппозиторий вводят во влагалище в положении лежа, как можно глубже, 1 раз/сут на ночь. При упорном течении вагинитов, вызванных Candida albicans, дополнительно назначают Пимафуцин, в форме таблеток для приема внутрь (по 1 таб.
Полезные советы
СОВЕТ №1
Перед началом применения препарата Пимафуцин во время беременности обязательно проконсультируйтесь с врачом. Только специалист сможет оценить показания к применению и решить, насколько безопасно использовать данный препарат в вашем случае.
СОВЕТ №2
Следуйте инструкции по применению Пимафуцина строго по назначению врача. Не превышайте дозировку и не продлевайте курс лечения без согласования с специалистом.
СОВЕТ №3
Во время лечения Пимафуцином избегайте употребления алкоголя, так как это может усилить побочные эффекты препарата и негативно сказаться на вашем здоровье и здоровье ребенка.